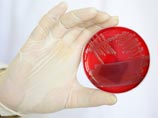

|
 |
 |
 |
| ||||||||||||
 |
Вокруг света
Кишечную палочку, убивающую европейцев, превратят в биотопливо
2:42PM Thursday, Jun 30, 2011
Кишечная палочка E.coli, ставшая причиной отравления пищевых продуктов по всему миру и гибели десятков человек, через пять лет может стать биотопливом, доступным для общего пользования, считает американский ученый. Несколько компаний работают над технологией, которая уже приносит результаты в лабораториях, однако пока не может обеспечить производство топлива в коммерческих масштабах, сообщил исследователь Джей Кислинг во время научно-технического форума Aspen Ideas Festival. Кислинг, исполнительный директор основанного Министерством энергетики США Объединенного института биоэнергетики, стал первопроходцем в области создания биотоплива на основе различных веществ от дрожжей до кишечной палочки и ожидает, что создание топлива из E.coli продвинется в ближайшее время, передает Reuters. Уже сейчас подобная технология используется для создания из кишечной палочки пластика, попадающего на прилавки магазинов в составе ковриков и другой продукции. И хотя в пластике из E.coli нет ничего опасного, компании обычно не сообщают потребителям о его необычном происхождении, сказал Кислинг. При попадании в организм человека кишечная палочка может быть очень опасной, и даже вызвать смерть. Недавно E.coli взбудоражила всю Европу, вызвав 47 смертей и настоящую панику в Германии. Хотя биотопливо обладает огромным потенциалом, способствующим снижению потребления ископаемого топлива, "пройдет еще много времени, прежде чем биотопливо станет серьезным конкурентом бензину", отметил Кислинг. Критический момент в этом вопросе может наступить не раньше, чем через 20 лет, добавил он.
По материалам NewsRu.com
Другие новости по теме
• "ГАЗ" выкупит земли под своими предприятиями…• Объем выдачи ипотеки в России за полгода вырос в 1,8 раза… • В Россию привезут эксклюзивную версию Range Rover… • Создатели Super Meat Boy начали работу над новым проектом… • Германия продлила срок действия антитеррористических законов… • Подмосковные дольщики превратились в невидимок… • Немецкая полиция разочаровалась в грифах-ищейках… • Тайгер Вудс разрекламирует японские лекарства… • В Грузии заочно арестовали Окруашвили… • В Китае открыли самый длинный в мире морской мост… • Aston Martin начнет разработку новых спорткаров… • КС РФ разрешил регистрироваться в домах на сельхозземлях… • Беспилотники Hermes получат англо-итальянские радары… • НАТО отказалось от помощи ФРГ в Ливии… • Американец заплатил выписанный 35 лет назад штраф в один доллар… • В Москве подешевела аренда жилья…
|
| News Central Home | News Central Resources | Portal News Resources | Help | Login |